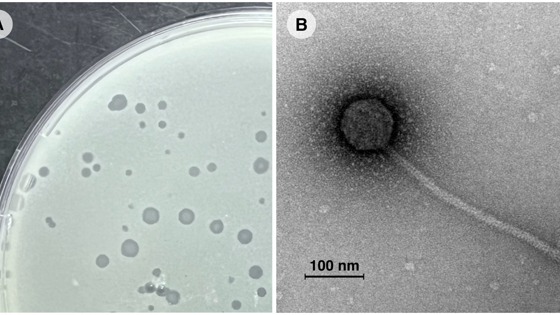

Новый бактериофаг поможет найти альтернативу антибиотикам для лечения туберкулеза

Ученые открыли и описали новый вирус, способный уничтожать микобактерии, среди которых возбудители таких опасных заболеваний как туберкулез и проказа. Обнаруженный вирус — микобактериофаг Vic9 — первый из выделенных на территории России. Он обладает уникальными генетическими особенностями, которые позволят узнать, как вирусы взаимодействуют с бактериями и как они эволюционируют, приспосабливаясь к разным жертвам. Полученные данные помогут разработать альтернативные методы лечения опасных бактериальных инфекций, в том числе устойчивых к антибиотикам. Результаты исследования, поддержанного грантом Российского научного фонда (РНФ), опубликованы в журнале Frontiers in Microbiology.
Бактериальные инфекции — одна из самых распространенных причин смертности во всем мире. При этом среди возбудителей все чаще встречаются разновидности, устойчивые к антибиотикам. Так, для некоторых форм туберкулеза с множественной лекарственной устойчивостью вероятность успешного лечения на сегодняшний день составляет не более 68%. Альтернативой или дополнением к традиционному лечению антибиотиками может стать фаготерапия — метод, при котором опасных бактерий заражают специальными вирусами — бактериофагами. Фаги проникают в клетки бактерий, разрушают их изнутри, одновременно размножаясь и образуя новое поколение вирусов. При этом они, как правило, нацелены на один бактериальный вид или даже штамм патогена (штамм — это вариант с особенными свойствами). Это делает фагов безопасными для пациента и его нормальной микрофлоры. Однако для подбора эффективного лечения важно располагать обширной коллекцией хорошо изученных бактериофагов. При этом необходимо знать, как устроен их жизненный цикл и какие бактерии они поражают.
Ученые из Федерального научно-клинического центра физико-химической медицины имени академика Ю.М. Лопухина Федерального медико-биологического агентства (Москва) с коллегами открыли и описали новый бактериальный вирус — микобактериофаг Vic9. Исследователи выделили его из образцов почвы с помощью бактерии Mycobacterium smegmatis. Этот микроорганизм часто используют в исследованиях, потому что он генетически близок туберкулезной палочке, но при этом безопасен для человека. Для получения бактериофага исследователи использовали метод накопительных культур: в раствор, содержащий частицы вируса из природы, но очищенный от всех микроорганизмов, добавили культуру Mycobacterium smegmatis. Это позволило размножиться только фагам, нацеленным на данную бактерию, среди которых был Vic9.
С помощью электронного микроскопа ученые определили, что Vic9 устроен как типичный микобактериофаг с головкой, содержащей генетический материал, и длинным хвостом, который он использует для прикрепления к бактерии. Также авторы изучили жизненный цикл фага и его способность убивать разные микобактерии. На четыре из шести тестируемых видов Vic9 не оказал влияния. Клетку своего хозяина Mycobacterium smegmatis он уничтожил примерно за два часа, после чего из нее выделилось 68 новых вирусных частиц. Vic9 также оказался способен слабо поражать клетки туберкулезной палочки Mycobacterium tuberculosis.
Авторы расшифровали геном Vic9 и сравнили его с генетическими последовательностями других бактериофагов. Результаты показали, что он входит в одну из ранее описанных групп вирусов микобактерий. При этом Vic9 оказался первым представителем этой группы, обнаруженным на территории Евразии. Другие подобные бактериофаги ранее выделялись лишь в США и Бразилии. Кроме того, ученые выявили в геноме несколько уникальных генов, которых нет у других похожих фагов. Эти особенности помогут понять, как эволюционируют фаги, приспосабливаясь к новым хозяевам, и как они взаимодействуют с бактериями. Авторы планируют детальнее изучить обнаруженные гены, чтобы определить, за выработку каких белков они отвечают, и какие преимущества это дает бактериофагу.
Исследователи планируют пополнять коллекцию описанных фагов, что в дальнейшем позволит рассматривать фаготерапию в качестве альтернативного метода лечения туберкулеза и других опасных заболеваний, вызываемых микобактериями.
«Кроме Vic9 мы выделили еще около 20 фагов, в том числе те, которые демонстрируют высокую активность против туберкулезной палочки. Мы планируем использовать разработанную систему методов, включая анализ жизненного цикла, для их детального исследования и пополнения нашей коллекции. Кроме того, требует внимания механизм, с помощью которого микобактерии уклоняются от иммунного ответа. Они могут выживать внутри макрофагов — иммунных клеток, предназначенных для их уничтожения. Возбудители туберкулеза также способны переходить в состояние, устойчивое к стандартной терапии. Мы хотим исследовать, как фаги будут воздействовать на микобактерии в таких защищенных условиях», — рассказывает участник исследования, поддержанного грантом РНФ, Егор Шитиков, доктор биологических наук, заведующий лабораторией молекулярной генетики микроорганизмов Федерального научно-клинического центра физико-химической медицины имени академика Ю.М. Лопухина ФМБА России.
В исследовании принимали участие сотрудники Федерального исследовательского центра «Фундаментальные основы биотехнологии» РАН (Москва), Государственного научного центра прикладной микробиологии и биотехнологии (Оболенск), Московского государственного университета имени М.В. Ломоносова (Москва) и Национального медицинского исследовательского центра фтизиопульмонологии и инфекционных заболеваний (Москва).